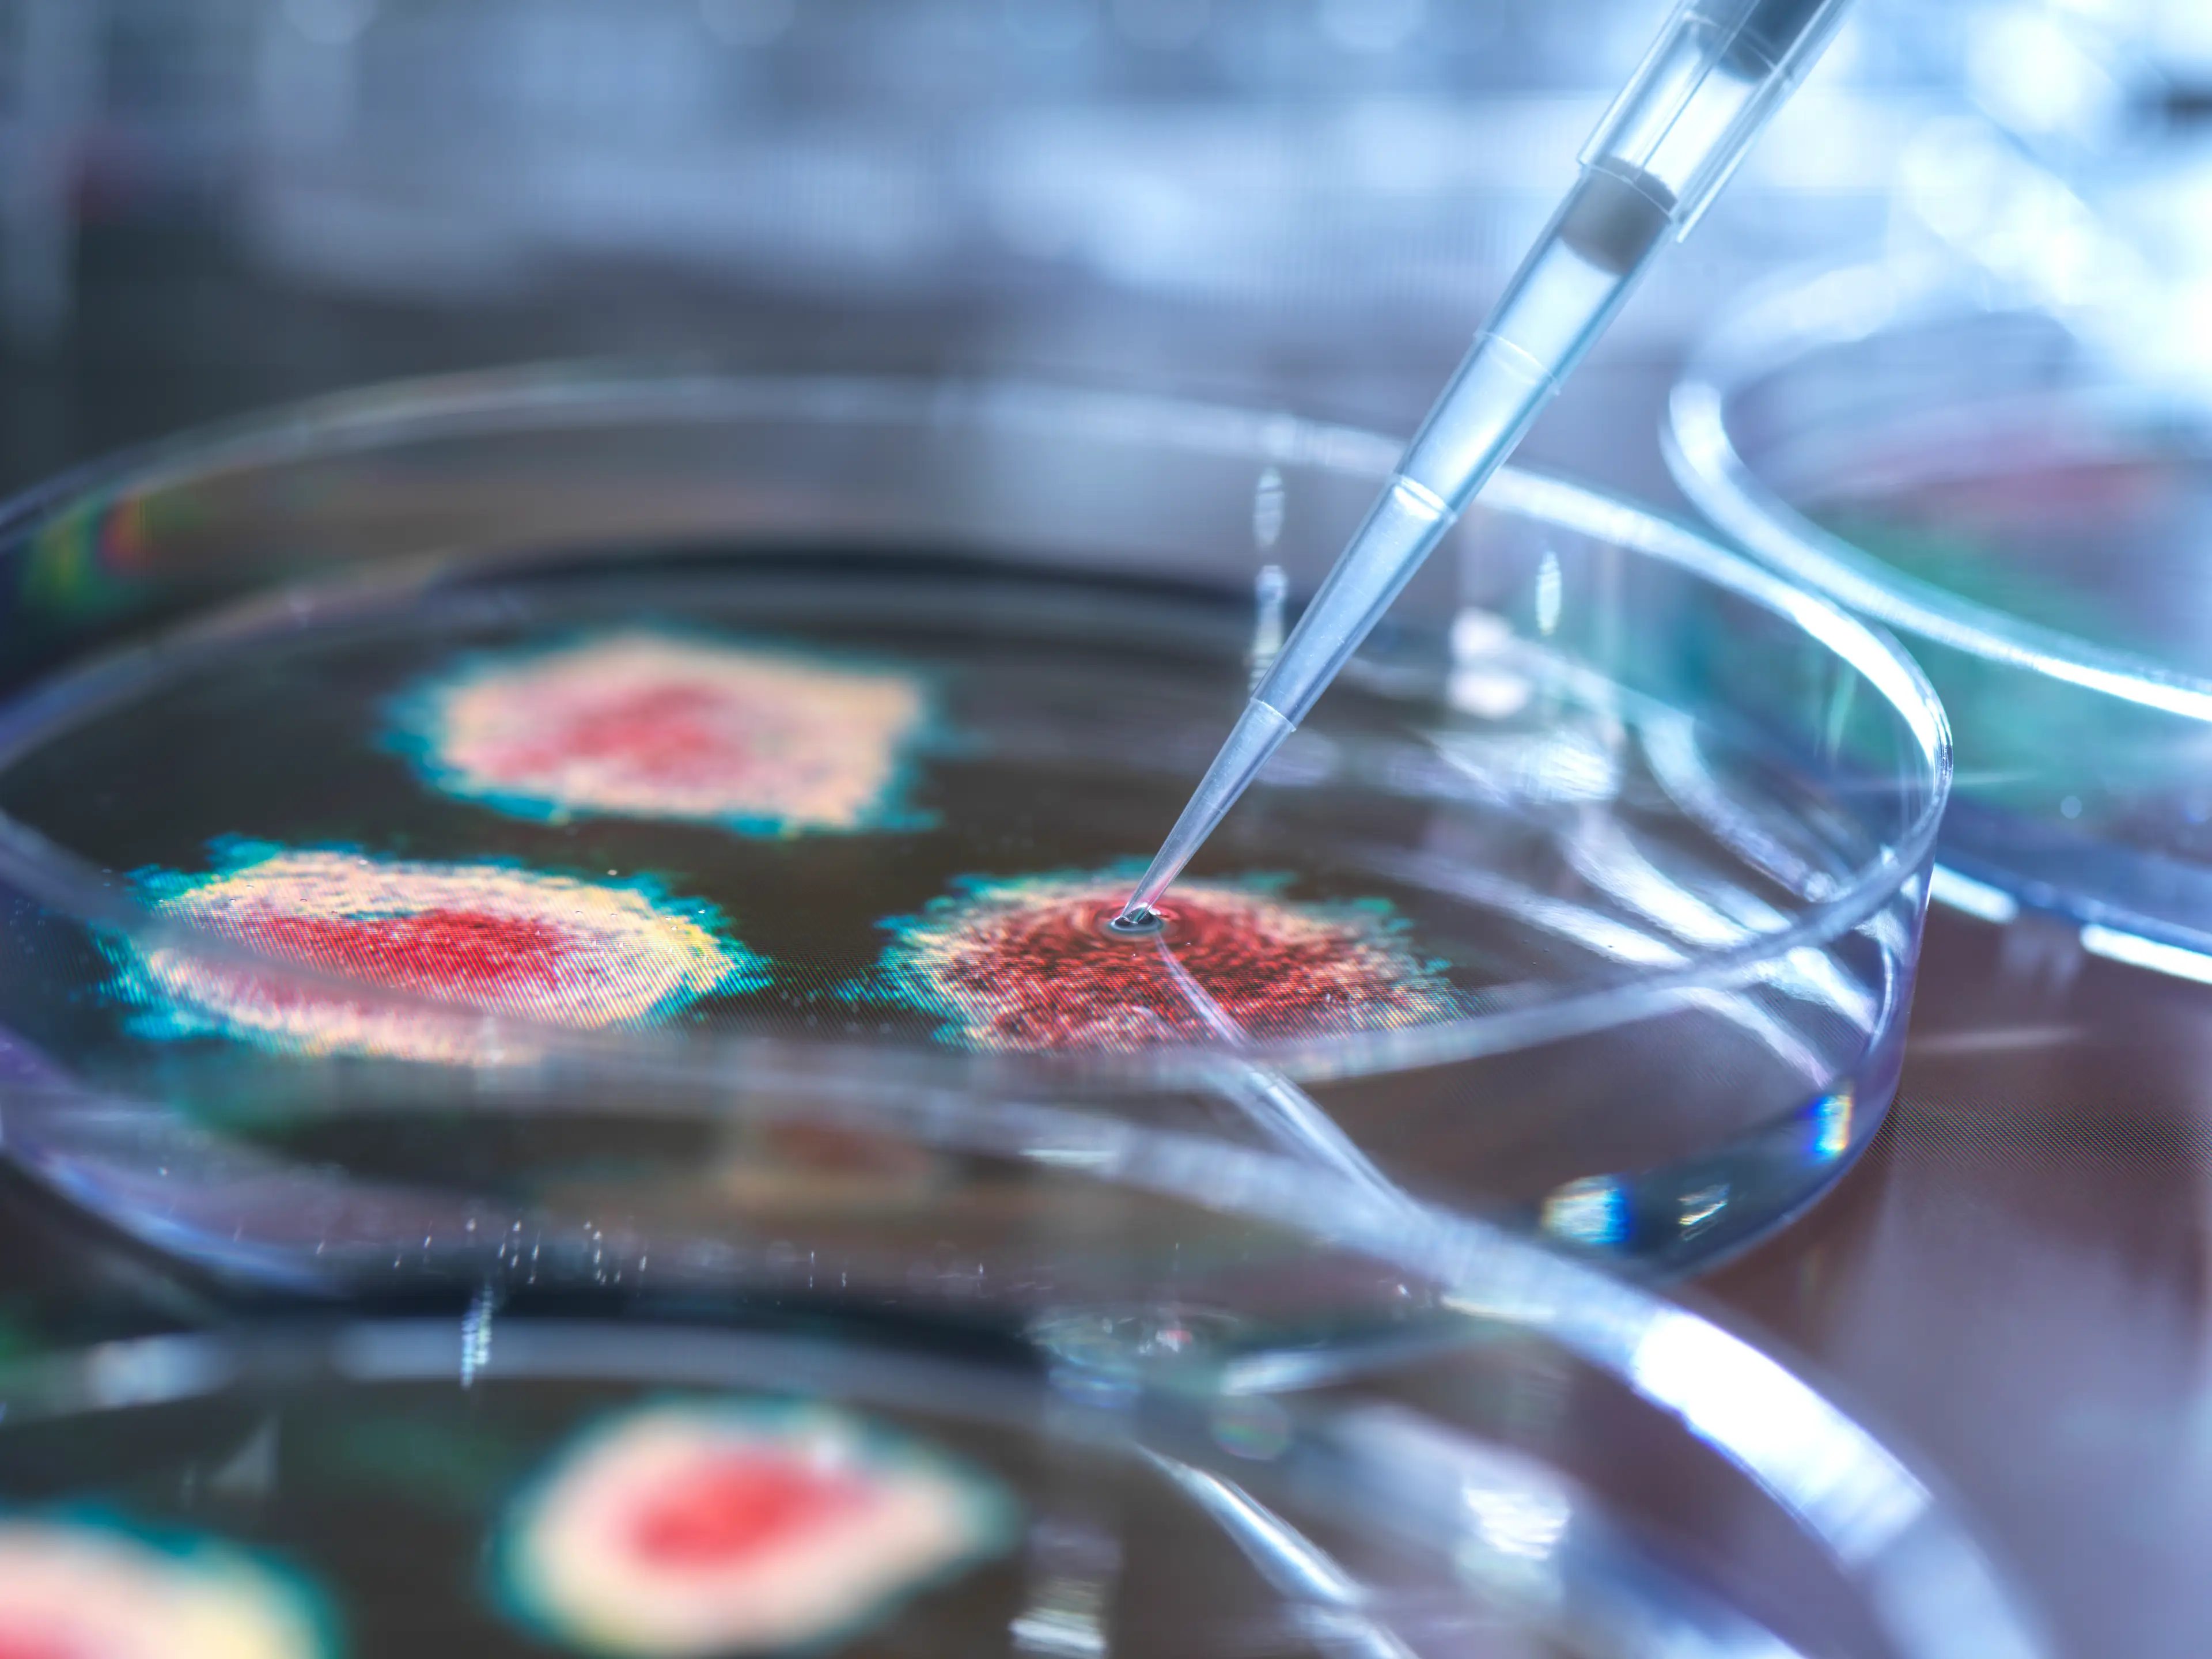
The virus found dates back 50,000 years. (TEK IMAGE/SCIENCE PHOTO LIBRARY)

The oldest human virus on record has been discovered by scientists after conducting research on bones believed to be 50,000 years old.
Researchers at the Federal University of São Paulo, Brazil, have been looking into the theory that a virus could have caused Neanderthals' extinction and have been analyzing two sets of Neanderthal remains to try find their answers.
The remains are believed to date back over 50,000 years, and were discovered in Chagyrskaya cave in Russia.
Scientists combed through their DNA data sets and searched for 'viral remnants in sequencing reads of Neanderthal genome data by mapping to adenovirus, herpesvirus and papillomavirus'.
Advert

These three groups are described as 'double stranded DNA viruses that may establish lifelong latency and can, produce persistent infections'.
Remnants of adenovirus, herpesvirus and papillomavirus were all found in the DNA, making them the oldest human viruses ever discovered.
Part of the study published last month read: "Sequencing reads mapped to extant viral genomes showed deamination patterns of ancient DNA and that these ancient viral genomes showed divergence consistent with the age of these samples and viral evolutionary rates."
The findings now present the idea that Neanderthals could have fallen ill with some of the same viruses that affect us to this day.
For example, adenovirus causes cold and flu-like illnesses and affects people of all ages any time of year.
The new findings replace a 31,600-year-old virus that was previously the oldest virus to have been discovered.
In 2021, scientists from the University of Copenhagen found the virus on two milk teeth.
The teeth was said to have 'concealed DNA from a pathogenic virus that was already rife and attacking human beings as far back as 31,600 years ago', the Lundbeck Foundation wrote at the time.
The find what they were looking for, the pair of teeth were ground up and partially pulverised.
The DNA they contained were then recorded in a so-called sequencing process.

Associate Professor Martin Sikora, who led the study, said of their research method: "This meant you could find the person’s own DNA, but in addition to that, also all the DNA from, for example, bacteria and viruses that was encapsulated in calcium deposits on the tooth or carried to the tooth via the person’s bloodstream."
Like in the new study, the 2021 findings also discovered adenovirus, which was first isolated in 1953.
With that in mind, the oldest samples of the virus had been only 70 years old - but it believed to date back much later than that.
Guest researcher at the University of Copenhagen, Sofie Holtsmark Nielsen explained: "When you look at the mutations that the virus has undergone in this short space of time, your immediate assumption might be that it’s a young virus. But it’s not."
Topics: Science, Health, News, World News